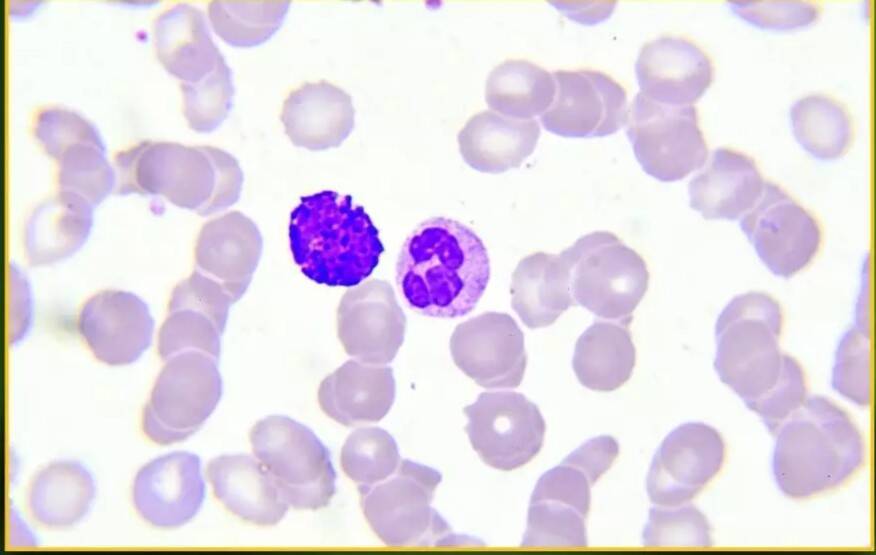
Why is Glioma called silent but deadly brain tumour?

While many turn to high-tech sleep hacks, an aging mattress is often the hidden culprit behind poor rest. Over seven to ten years, structural decay leads to spinal misalignment and trapped heat, which summer temperatures only amplify. Experts warn that losing support and accumulating allergens can cause chronic pain and micro-awakenings, making a mattress upgrade a vital wellness priority.


The 1-minute gait test involves walking a set distance. Typically, the set distance is for about 4 metres, where individuals are told to walk at normal pace, and time taken to cover distance is measured. According to research published in a journal, walking speed can reveal a lot about one's biological age. Walking speed >1.2 m/s indicates low risk.


I used to struggle with tracking my meals and staying consistent. Then I found Zylo AI, it made calorie tracking effortless. Just a quick photo, and I knew exactly what I was eating. I have Lost over 12 Pounds (Kgs) in 30 days.
Over time, I learned my habits, made smarter food choices, and finally reached my goal weight. Zylo didn’t just count calories; it guided me toward balance and progress.
Start your journey with Zylo AI track smarter, live better.

Dr. Saurabh Sethi warns that late-night dinners disrupt the body's circadian rhythm, lowering insulin sensitivity, slowing fat burning, and affecting sleep. Eating earlier improves blood sugar control, digestion, and recovery. Even a small shift helps, especially for those with diabetes or fatty liver, as late meals can significantly worsen glucose spikes and metabolic health.


NIT Rourkela has patented an intelligent surveillance system using thermal imaging and gait recognition to detect unauthorized individuals in restricted areas. The automated, non-intrusive system tracks movement across checkpoints, works in low-light conditions, and stores data for analysis, offering enhanced security for campuses, industries, and high-security environments.


There is no scientific evidence that lemon, ENO, black pepper, or black salt can dissolve internal stones. Such stones are mineral deposits that require medical evaluation and treatment. Don't trust quick-fix remedies for serious conditions. Understanding how your body actually works helps you avoid misleading and risky claims.


A persistent cough lasting over two weeks may signal tuberculosis, especially if accompanied by fever, night sweats, weight loss, or fatigue, according to experts. Early detection through sputum tests, X-rays, or molecular diagnostics ensures timely treatment. Awareness of these warning signs is crucial to prevent complications and stop the spread of this treatable disease.


I’d tried every diet and app before, but nothing stuck. Then I discovered Zylo AI. Instead of guessing, I started tracking my meals with a single photo. Zylo instantly showed me calories, protein, and nutrients no manual logging, no confusion.
Slowly, I built better habits and stayed consistent. In just months, I lost 26 kgs and gained real confidence. Zylo didn’t just track my food — it changed how I live.
Track smarter. Eat better and the best part its Free Calorie Tracker

Parsvottanasana, or Intense Side Stretch Pose, is a key yoga asana that boosts flexibility, strengthens the spine, legs, and lower back, and improves balance and digestion. Practiced from Tadasana, it involves a forward bend with deep breathing for 20-60 seconds. Beginners or those with back issues should perform it under expert supervision.


A new study from Swansea University finds that teenagers who follow healthier diets report fewer symptoms of depression, while poor eating habits are linked to emotional distress. Researchers stress that adolescence is a crucial period for brain development, making nutrition important for mental health. They also call for broader research beyond depression to understand overall wellbeing.

Glioma, as explained by Dr Mukund Agrawal, is a brain tumour arising from glial cells with varying growth rates. Often called silent but deadly, symptoms like headaches, seizures, and memory changes may go unnoticed. Diagnosis involves MRI and tests, while treatment includes surgery, radiation, and therapies. Early detection improves outcomes and quality of life.


Glioma, as explained by Dr Aniruddha Vasant More, is a brain or spinal cord tumour arising from glial cells. Causes are often unclear, though genetics and radiation may play a role. Symptoms include unusual headaches, seizures, and memory changes. Diagnosis uses MRI and biopsy, while treatment includes surgery, radiation, and advanced targeted therapies.
